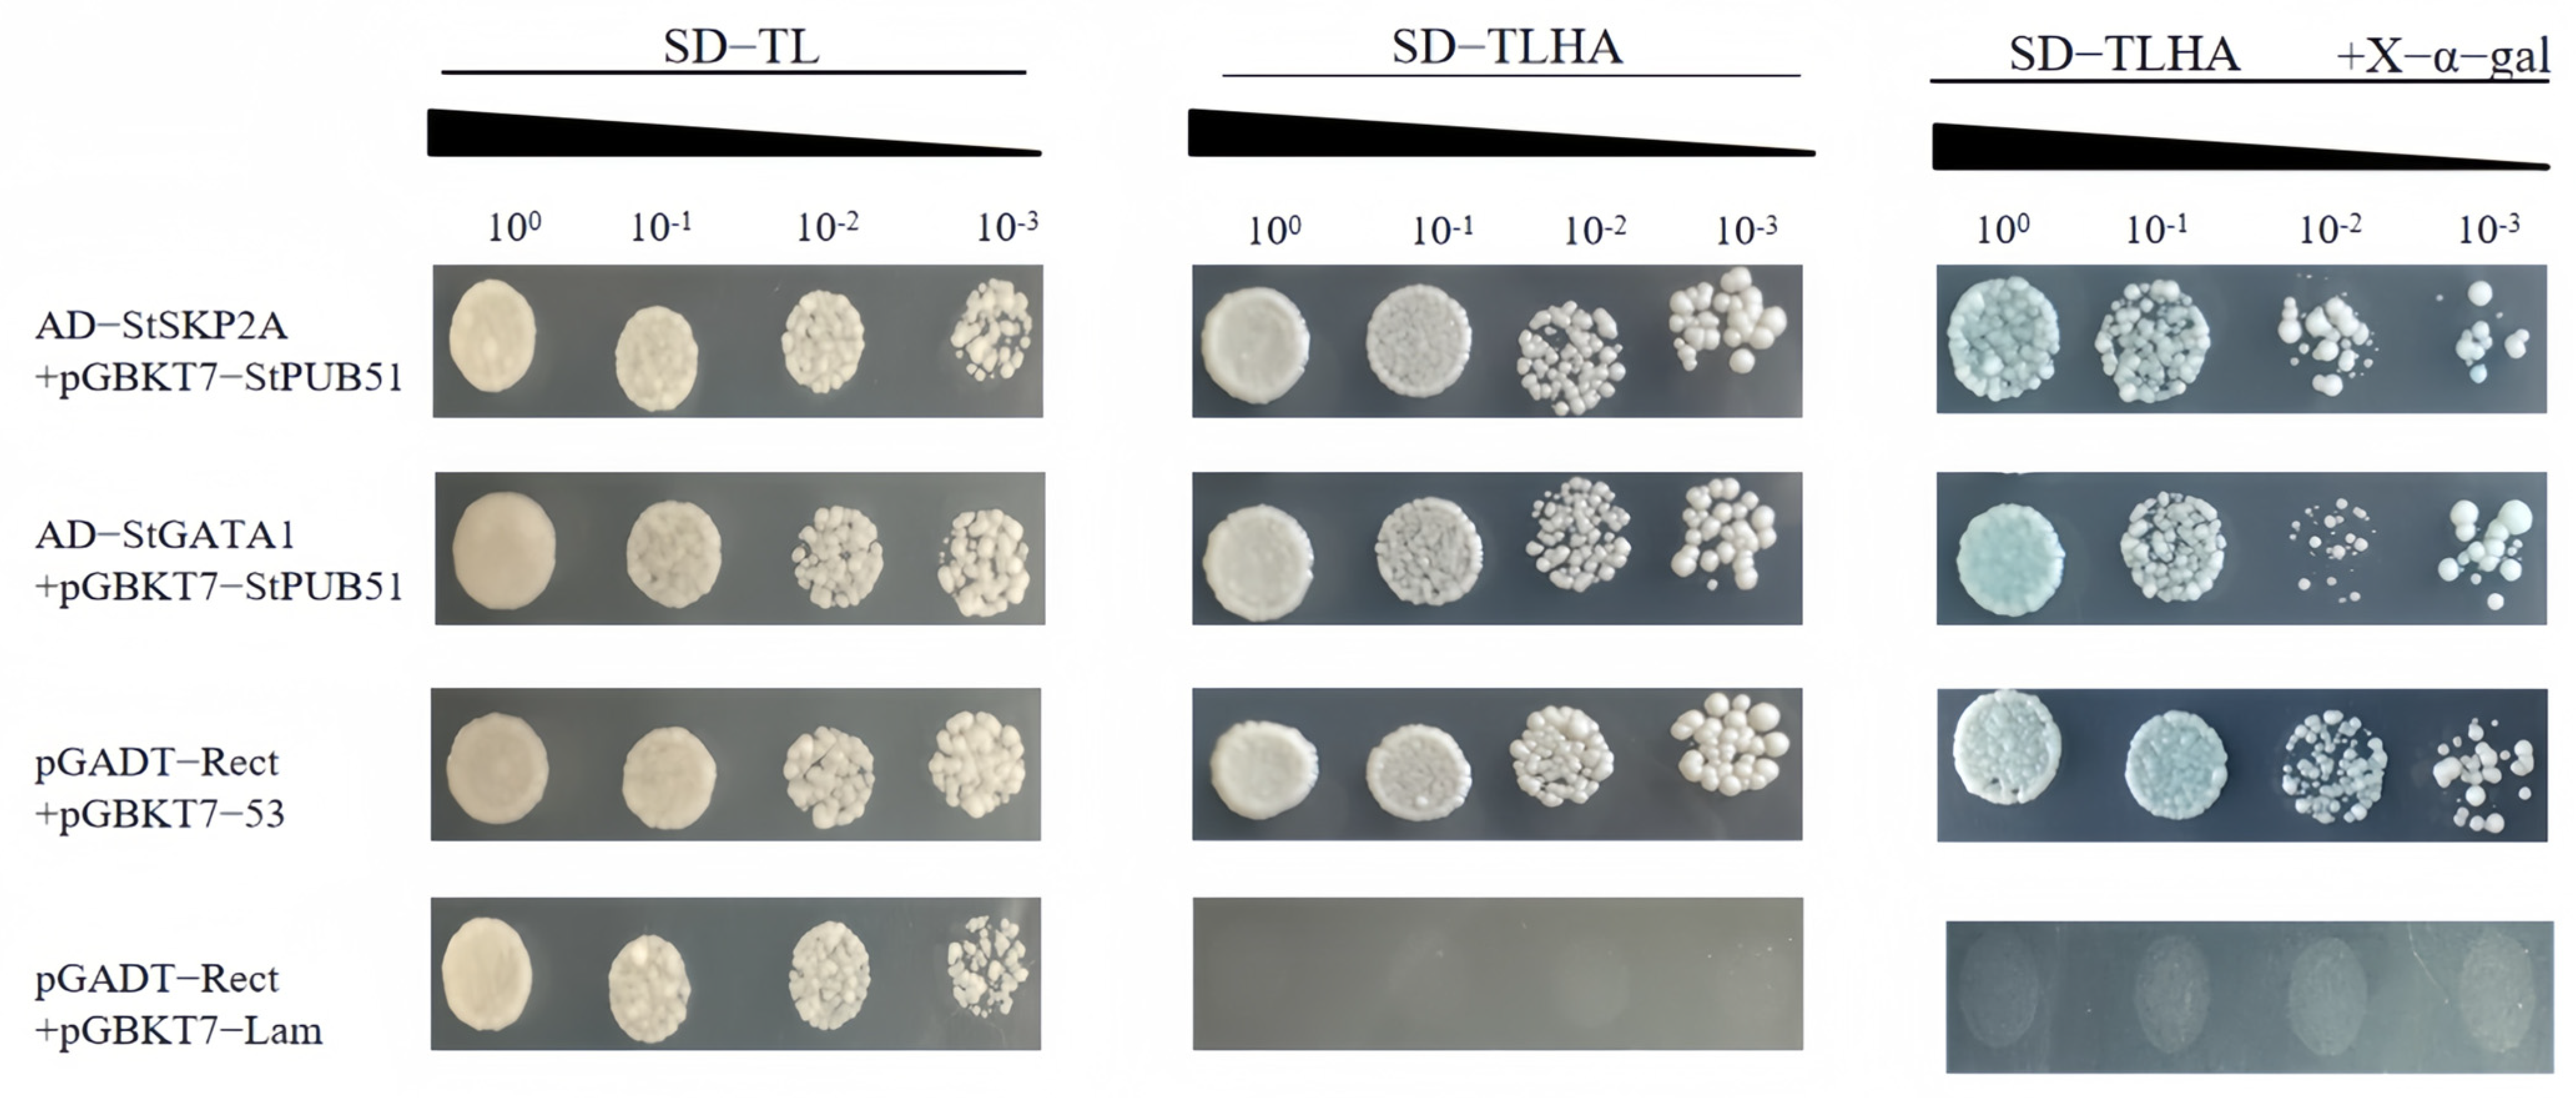
Ijms 25 12961 g005

Ubiquitin Ligase U-Box51 Positively Regulates Drought Stress in Potato (Solanum tuberosum L.)
Abstract
1. Introduction
2. Results
2.1. Bioinformatics Analysis of StPUB51
2.2. Tissue Specificity of Potato StPUB51 and Expression Analysis Under PEG 6000 Stress
2.3. Subcellular Localization Assay
2.4. Genetic Transformation and Characterization of Transgenic Plants StPUB51
2.5. Drought-Resistance Analysis of StPUB51 in Potato
2.6. Yeast Two-Hybrid Identification of StPUB51 Interacting Proteins
2.7. BiFC Experiments to Validate StPUB51-Interacting Proteins
3. Discussion
4. Materials and Methods
4.1. Plant Materials and Growth Conditions
4.2. Cloning of StPUB51
4.3. Bioinformatics and Expression Analysis of StPUB51
4.4. Analysis of StPUB51 Expression by qRT-PCR
4.5. Subcellular Localization of StPUB51 Protein
4.6. Construction of Plant Expression Vectors
4.7. Genetic Transformation of Potato StPUB51
4.8. Drought-Stress Treatment of Transgenic Plants
4.9. Yeast Two-Hybrid Experiment
4.10. Yeast Rotary Validation Analysis
4.11. Complementary Analysis of Bimolecular Fluorescence
5. Conclusions
Supplementary Materials
Author Contributions
Funding
Institutional Review Board Statement
Informed Consent Statement
Data Availability Statement
Acknowledgments
Conflicts of Interest
References
- Obidiegwu, J.E.; Bryan, G.J.; Jones, H.G.; Prashar, A. Coping with drought: Stress and adaptive responses in potato and perspectives for improvement. Front. Plant Sci. 2015, 6, 542. [Google Scholar] [CrossRef] [PubMed]
- Vierstra, R.D. The ubiquitin-26S proteasome system at the nexus of plant biology. Nat. Rev. Mol. Cell Biol. 2009, 10, 385–397. [Google Scholar] [CrossRef] [PubMed]
- Dye, B.T. Schulman BA. Structural mechanisms underlying posttranslational modification by ubiquitin-like proteins. Annu. Rev. Biophys. Biomol. Struct. 2007, 36, 131–150. [Google Scholar] [CrossRef] [PubMed]
- Shu, K.; Yang, W. E3 ubiquitin ligases: Ubiquitous actors in plant development and abiotic stress responses. Plant Cell Physiol. 2017, 58, 1461–1476. [Google Scholar] [CrossRef]
- Koegl, M.; Hoppe, T.; Schlenker, S.; Ulrich, H.D.; Mayer, T.U.; Jentsch, S. A novel ubiquitination factor E4 is involved in multiubiquitin chain assembly. Cell 1999, 96, 635–644. [Google Scholar] [CrossRef]
- Aravind, L.; Koonin, E.V. The U box is a modified RING finger—A common domain in ubiquitination. Curr. Biol. 2000, 10, R132–R134. [Google Scholar] [CrossRef]
- Kim, D.Y.; Lee, Y.J.; Hong, M.J.; Kim, J.H.; Seo, Y.W. Genome wide analysis of U-Box E3 ubiquitin ligases in wheat (Triticum aestivum L.). Int. J. Mol. Sci. 2021, 22, 2699. [Google Scholar] [CrossRef]
- Mao, X.; Yu, C.; Li, L.; Wang, M.; Yang, L.; Zhang, Y.; Zhang, Y.; Wang, J.; Li, C.; Reynolds, M.P.; et al. How many faces does the plant U-Box E3 ligase have? Int. J. Mol. Sci. 2022, 23, 2285. [Google Scholar] [CrossRef]
- Cho, S.K.; Chung, H.S.; Ryu, M.Y.; Park, M.J.; Lee, M.M.; Bahk, Y.Y.; Kim, J.; Pai, H.S.; Kim, W.T. Heterologous expression and molecular and cellular characterization of CaPUB1 encoding a hot pepper U-Box E3 ubiquitin ligase homolog. Plant Physiol. 2006, 142, 1664–1682. [Google Scholar] [CrossRef]
- Bergler, J.; Hoth, S. Plant U-box armadillo repeat proteins AtPUB18 and AtPUB19 are involved in salt inhibition of germination in Arabidopsis. Plant Biol. 2011, 13, 725–730. [Google Scholar] [CrossRef]
- Liu, L.; Cui, F.; Li, Q.; Yin, B.; Zhang, H.; Lin, B.; Wu, Y.; Xia, R.; Tang, S.; Xie, Q. The endoplasmic reticulum-associated degradation is necessary for plant salt tolerance. Cell Res. 2011, 21, 957–969. [Google Scholar] [CrossRef] [PubMed]
- Park, J.J.; Yi, J.; Yoon, J.; Cho, L.H.; Ping, J.; Jeong, H.J.; Cho, S.K.; Kim, W.T.; An, G. OsPUB15, an E3 ubiquitin ligase, functions to reduce cellular oxidative stress during seedling establishment. Plant J. 2011, 65, 194–205. [Google Scholar] [CrossRef] [PubMed]
- Seo, K.I.; Song, E.; Chung, S.; Lee, J.H. Roles of various cullin-RING E3 ligases involved in hormonal and stress responses in plants. J. Plant Biol. 2012, 55, 421–428. [Google Scholar] [CrossRef]
- Raab, S.; Drechsel, G.; Zarepour, M.; Hartung, W.; Koshiba, T.; Bittner, F.; Hoth, S. Identification of a novel E3 ubiquitin ligase that is required for suppression of premature senescence in Arabidopsis. Plant J. 2009, 59, 39–51. [Google Scholar] [CrossRef]
- Sakamoto, T.; Kitano, H.; Fujioka, S. An E3 ubiquitin ligase, ERECT LEAF1, functions in brassinosteroid signaling of rice. Plant Signal. Behav. 2013, 8, e27117. [Google Scholar] [CrossRef]
- Liu, Y.; Bassham, D.C. Autophagy: Pathways for self-eating in plant cells. Annu. Rev. Plant Biol. 2012, 63, 215–237. [Google Scholar] [CrossRef]
- Wang, H.; Lu, Y.; Jiang, T.; Berg, H.; Li, C.; Xia, Y. The Arabidopsis U-box/ARM repeat E3 ligase AtPUB4 influences growth and degeneration of tapetal cells, and its mutation leads to conditional male sterility. Plant J. 2013, 74, 511–523. [Google Scholar] [CrossRef]
- Samuel, M.A.; Mudgil, Y.; Salt, J.N.; Delmas, F.; Ramachandran, S.; Chilelli, A.; Goring, D.R. Interactions between the S-domain receptor kinases and AtPUB-ARM E3 ubiquitin ligases suggest a conserved signaling pathway in Arabidopsis. Plant Physiol. 2008, 147, 2084–2095. [Google Scholar] [CrossRef]
- Zhang, J.; Rea, A.C.; Fu, T.; Ma, C.; Nasrallah, J.B. Exploring the role of a stigma-expressed plant U-box gene in the pollination responses of transgenic self-incompatible Arabidopsis thaliana. Plant Reprod. 2014, 27, 59–68. [Google Scholar] [CrossRef]
- Indriolo, E.; Tharmapalan, P.; Wright, S.I.; Goring, D.R. The ARC1 E3 ligase gene is frequently deleted in self-compatible Brassicaceae species and has a conserved role in Arabidopsis lyrata self-pollen rejection. Plant Cell 2012, 24, 4607–4620. [Google Scholar] [CrossRef]
- Trenner, J.; Monaghan, J.; Saeed, B.; Quint, M.; Shabek, N.; Trujillo, M. Evolution and functions of plant U-Box proteins: From protein quality control to signaling. Annu. Rev. Plant Biol. 2022, 73, 93–121. [Google Scholar] [CrossRef] [PubMed]
- Wiborg, J.; O’Shea, C.; Skriver, K. Biochemical function of typical and variant Arabidopsis thaliana U-box E3 ubiquitin-protein ligases. Biochem. J. 2008, 413, 447–457. [Google Scholar] [CrossRef] [PubMed]
- Hu, H.; Dong, C.; Sun, D.; Hu, Y.; Xie, J. Genome-wide identification and analysis of U-Box E3 ubiquitin⁻protein ligase gene family in banana. Int. J. Mol. Sci. 2018, 19, 3874. [Google Scholar] [CrossRef]
- Mudgil, Y.; Shiu, S.H.; Stone, S.L.; Salt, J.N.; Goring, D.R. A large complement of the predicted Arabidopsis ARM repeat proteins are members of the U-box E3 ubiquitin ligase family. Plant Physiol. 2004, 134, 59–66. [Google Scholar] [CrossRef]
- Samuel, M.A.; Salt, J.N.; Shiu, S.H.; Goring, D.R. Multifunctional arm repeat domains in plants. Int. Rev. Cytol. 2006, 253, 1–26. [Google Scholar] [CrossRef]
- Zhu, J.K. Abiotic stress signaling and responses in plants. Cell 2016, 167, 313–324. [Google Scholar] [CrossRef]
- Blum, A. Osmotic adjustment is a prime drought stress adaptive engine in support of plant production. Plant Cell Environ. 2017, 40, 4–10. [Google Scholar] [CrossRef]
- Yee, D.; Goring, D.R. The diversity of plant U-box E3 ubiquitin ligases: From upstream activators to downstream target substrates. J. Exp. Bot. 2009, 60, 1109–1121. [Google Scholar] [CrossRef]
- Kong, L.; Cheng, J.; Zhu, Y.; Ding, Y.; Meng, J.; Chen, Z.; Xie, Q.; Guo, Y.; Li, J.; Yang, S.; et al. Degradation of the ABA co-receptor ABI1 by PUB12/13 U-box E3 ligases. Nat. Commun. 2015, 6, 8630. [Google Scholar] [CrossRef]
- Zhao, J.; Zhao, L.; Zhang, M.; Zafar, S.A.; Fang, J.; Li, M.; Zhang, W.; Li, X. Arabidopsis E3 ubiquitin ligases PUB22 and PUB23 negatively regulate drought tolerance by targeting aba receptor PYL9 for degradation. Int. J. Mol. Sci. 2017, 18, 1841. [Google Scholar] [CrossRef]
- Mmadi, M.A.; Dossa, K.; Wang, L.; Zhou, R.; Wang, Y.; Cisse, N.; Sy, M.O.; Zhang, X. Functional characterization of the versatile MYB gene family uncovered their important roles in plant development and responses to drought and waterlogging in sesame. Genes 2017, 8, 362. [Google Scholar] [CrossRef] [PubMed]
- Wei, Q.; Zhang, F.; Sun, F.; Luo, Q.; Wang, R.; Hu, R.; Chen, M.; Chang, J.; Yang, G.; He, G. A wheat MYB transcriptional repressor TaMyb1D regulates phenylpropanoid metabolism and enhances tolerance to drought and oxidative stresses in transgenic tobacco plants. Plant Sci. 2017, 265, 112–123. [Google Scholar] [CrossRef] [PubMed]
- Wang, N.; Zhang, W.; Qin, M.; Li, S.; Qiao, M.; Liu, Z.; Xiang, F. Drought tolerance conferred in soybean (Glycine max. L) by GmMYB84, a novel R2R3-MYB transcription factor. Plant Cell Physiol. 2017, 58, 1764–1776. [Google Scholar] [CrossRef] [PubMed]
- Asad, M.; Zakari, S.; Zhao, Q.; Zhou, L.; Ye, Y.; Cheng, F. Abiotic stresses intervene with ABA signaling to induce destructive metabolic pathways leading to death: Premature leaf senescence in plants. Int. J. Mol. Sci. 2019, 20, 256. [Google Scholar] [CrossRef]
- Zhao, Y.; Medrano, L.; Ohashi, K.; Fletcher, J.C.; Yu, H.; Sakai, H.; Meyerowitz, E.M. HANABA TARANU is a GATA transcription factor that regulates shoot apical meristem and flower development in Arabidopsis. Plant Cell 2004, 16, 2586–2600. [Google Scholar] [CrossRef]
- Chiang, Y.H.; Zubo, Y.O.; Tapken, W.; Kim, H.J.; Lavanway, A.M.; Howard, L.; Pilon, M.; Kieber, J.J.; Schaller, G.E. Functional characterization of the GATA transcription factors GNC and CGA1 reveals their key role in chloroplast development, growth, and division in Arabidopsis. Plant Physiol. 2012, 160, 332–348. [Google Scholar] [CrossRef]
- Zhang, Y.; Wang, L. The WRKY transcription factor superfamily: Its origin in eukaryotes and expansion in plants. BMC Evol. Biol. 2005, 5, 1. [Google Scholar] [CrossRef]
- Mittler, R.; Vanderauwera, S.; Suzuki, N.; Miller, G.; Tognetti, V.B.; Vandepoele, K.; Gollery, M.; Shulaev, V.; Van Breusegem, F. ROS signaling: The new wave? Trends Plant Sci. 2011, 16, 300–309. [Google Scholar] [CrossRef]
- Majeed, Y.; Zhang, N.; Zhu, X.; Liu, S.; Si, H. StMAPK10 gene functional identification and analysis in drought resistance of potato crop (Solanum tuberosum L.). Physiol. Plant. 2024, 176, e14362. [Google Scholar] [CrossRef]
- Gill, S.S.; Tuteja, N. Reactive oxygen species and antioxidant machinery in abiotic stress tolerance in crop plants. Plant Physiol. Biochem. 2010, 48, 909–930. [Google Scholar] [CrossRef]
- Noctor, G.; Reichheld, J.P.; Foyer, C.H. ROS-related redox regulation and signaling in plants. Semin. Cell Dev. Biol. 2018, 80, 3–12. [Google Scholar] [CrossRef] [PubMed]
- Madhulika, S.; Jitendra, K.; Samiksha, S.; Singh, V.P.; Prasad, S.M. Roles of osmoprotectants in improving salinity and drought tolerance in plants: A review. Rev. Environ. Sci. Biotechnol. 2015, 14, 407–426. [Google Scholar] [CrossRef]
- Lee, S.; Seo, P.J.; Lee, H.J.; Park, C.M. A NAC transcription factor NTL4 promotes reactive oxygen species production during drought-induced leaf senescence in Arabidopsis. Plant J. 2012, 70, 831–844. [Google Scholar] [CrossRef] [PubMed]
- Gunes, A.; Inal, A.; Alpaslan, M.; Eraslan, F.; Bagci, E.G.; Cicek, N. Salicylic acid induced changes on some physiological parameters symptomatic for oxidative stress and mineral nutrition in maize (Zea mays L.) grown under salinity. J. Plant Physiol. 2007, 164, 728–736. [Google Scholar] [CrossRef]
- Lalonde, S.; Ehrhardt, D.W.; Loqué, D.; Chen, J.; Rhee, S.Y.; Frommer, W.B. Molecular and cellular approaches for the detection of protein-protein interactions: Latest techniques and current limitations. Plant J. 2008, 53, 610–635. [Google Scholar] [CrossRef]
- Bi, C.L.; Liu, X.; Zhang, X.Y. The function of F-box protein in plant growth and development. Yi Chuan 2006, 28, 1337–1342. [Google Scholar] [CrossRef]
- Nguyen, K.M.; Busino, L. The biology of F-box proteins: The SCF family of E3 Ubiquitin ligases. Adv. Exp. Med. Biol. 2020, 1217, 111–122. [Google Scholar] [CrossRef]
- Qu, L.; Sun, M.; Li, X.; He, R.; Zhong, M.; Luo, D.; Liu, X.; Zhao, X. The Arabidopsis F-box protein FOF2 regulates ABA-mediated seed germination and drought tolerance. Plant Sci. 2020, 301, 110643. [Google Scholar] [CrossRef]
- Reyes, J.C.; Muro-Pastor, M.I.; Florencio, F.J. The GATA family of transcription factors in Arabidopsis and rice. Plant Physiol. 2004, 134, 1718–1732. [Google Scholar] [CrossRef]
- Hudson, D.; Guevara, D.; Yaish, M.W.; Hannam, C.; Long, N.; Clarke, J.D.; Bi, Y.M.; Rothstein, S.J. GNC and CGA1 modulate chlorophyll biosynthesis and glutamate synthase (GLU1/Fd-GOGAT) expression in Arabidopsis. PLoS ONE 2011, 6, e26765. [Google Scholar] [CrossRef]
- Zhang, N.; Si, H.; Wang, D. Cloning of rd29A gene promoter from Arabidopsis thaliana and its application in stress-resistance transgenic Potato. Acta Agron. Sin. 2005, 31, 159–164. [Google Scholar] [CrossRef]
- Rao, X.; Huang, X.; Zhou, Z.; Lin, X. An improvement of the 2ˆ(-delta delta CT) method for quantitative real-time polymerase chain reaction data analysis. Biostat. Bioinform. Biomath. 2013, 3, 71–85. [Google Scholar]
- Wang, F. Identification of StERF109 Gene Function in Potato. Master’s Thesis, Gansu Agricultural University, Lanzhou, China, 2021. [Google Scholar] [CrossRef]
- Qi, X.; Tang, X.; Liu, W.; Fu, X.; Luo, H.; Ghimire, S.; Zhang, N.; Si, H. A potato RING-finger protein gene StRFP2 is involved in drought tolerance. Plant Physiol. Biochem. 2020, 146, 438–446. [Google Scholar] [CrossRef] [PubMed]
- Li, S.; Zhang, N.; Zhu, X.; Ma, R.; Yang, J.; Tang, X.; Si, H. Enhanced drought tolerance with artificial microRNA-mediated StProDH1 gene silencing in potato. Crop Sci. 2020, 60, 1462–1471. [Google Scholar] [CrossRef]
- Hayta, S.; Smedley, M.A.; Li, J.; Harwood, W.A.; Gilmartin, P.M. Agrobacterium-mediated transformation systems of Primula vulgaris. Plant Methods 2018, 14, 93. [Google Scholar] [CrossRef]
- Si, H.; Xie, C.H.; Liu, J. An efficient protocol for Agrobacterium-mediated transformation with microtuber and the induction of an antisense class I patatin gene into potato. Acta Agron. Sin. 2003, 29, 801–805. [Google Scholar] [CrossRef]
- Giannopolitis, C.N.; Ries, S.K. Superoxide dismutases: I. Occurrence in higher plants. Plant Physiol. 1977, 59, 309–314. [Google Scholar] [CrossRef]
- Maehly, A.C.; Chance, B. The assay of catalases and peroxidases. Methods Biochem. Anal. 1954, 1, 357–424. [Google Scholar] [CrossRef]
- Aebi, H. Catalase in vitro. Methods Enzymol. 1984, 105, 121–126. [Google Scholar] [CrossRef]
- Heath, R.L.; Packer, L. Photoperoxidation in isolated chloroplasts: I. Kinetics and stoichiometry of fatty acid peroxidation. Arch. Biochem. Biophys. 1968, 125, 189–198. [Google Scholar] [CrossRef]
- Wang, K.; Zhang, N.; Fu, X.; Zhang, H.; Liu, S.; Pu, X.; Wang, X.; Si, H. StTCP15 regulates potato tuber sprouting by modulating the dynamic balance between abscisic acid and gibberellic acid. Front. Plant Sci. 2022, 13, 1009552. [Google Scholar] [CrossRef] [PubMed]
- Fields, S.; Song, O. A novel genetic system to detect protein-protein interactions. Nature 1989, 340, 245–246. [Google Scholar] [CrossRef] [PubMed]
- Brückner, A.; Polge, C.; Lentze, N.; Auerbach, D.; Schlattner, U. Yeast two-hybrid, a powerful tool for systems biology. Int. J. Mol. Sci. 2009, 10, 2763–2788. [Google Scholar] [CrossRef] [PubMed]
- Hu, C.D.; Chinenov, Y.; Kerppola, T.K. Visualization of interactions among bZIP and Rel family proteins in living cells using bimolecular fluorescence complementation. Mol. Cell 2002, 9, 789–798. [Google Scholar] [CrossRef]

| NCBI Accession No. | PGSC ID | Annotations | Subcellular Localization |
|---|---|---|---|
| XM_015312788.1 | Soltu.DM.04G025280.1 | F-box/RNI-like superfamily protein | Nucleus |
| XM_006355679.2 | Soltu.DM.05G023550.1 | GATA transcription factor | Nucleus |
| XM_006346493 | Soltu.DM.07G011150.1 | cytidine deaminase | Nucleus |
| XM_006360024 | Soltu.DM.07G025540.1 | polyubiquitin | Nucleus |
| XM_006350714 | Soltu.DM.06G031560.1 | PGR5-like protein 1B, chloroplastic | Chloroplast |
| XM_006345193.2 | Soltu.DM.12G026280.1 | oligouridylate binding protein 1B | Chloroplast |
| XM_006349677.2 | Soltu.DM.09G020540.1 | Primosome PriB/single-strand DNA-binding | Nucleus |
| XM_006339612.2 | Soltu.DM.01G034630.1 | Mitochondrial substrate carrier family protein | Mitochondrion |
| XM_006358242.2 | Soltu.DM.07G003310.1 | Raffinose synthase family protein | Chloroplast, Cytoplasm |
| XM_006355002 | Soltu.DM.04G003360.1 | 2-oxoglutarate (2OG) and Fe(II)-dependent oxygenase superfamily protein | Cytoplasm |
| XM_006350817 | Soltu.DM.06G032790.1 | PAP/OAS1 substrate-binding domain superfamily | Chloroplast, Nucleus |
| XM_006359236.2 | Soltu.DM.04G005650.1 | conserved hypothetical protein | Cell membrane, Chloroplast, Nucleus |
Disclaimer/Publisher’s Note: The statements, opinions and data contained in all publications are solely those of the individual author(s) and contributor(s) and not of MDPI and/or the editor(s). MDPI and/or the editor(s) disclaim responsibility for any injury to people or property resulting from any ideas, methods, instructions or products referred to in the content. |
© 2024 by the authors. Licensee MDPI, Basel, Switzerland. This article is an open access article distributed under the terms and conditions of the Creative Commons Attribution (CC BY) license (https://creativecommons.org/licenses/by/4.0/).
Share and Cite
Wei, M.; Ghimire, S.; Rijal, A.; Wang, K.; Zhang, H.; Si, H.; Tang, X. Ubiquitin Ligase U-Box51 Positively Regulates Drought Stress in Potato (Solanum tuberosum L.). Int. J. Mol. Sci. 2024, 25, 12961. https://doi.org/10.3390/ijms252312961
Wei M, Ghimire S, Rijal A, Wang K, Zhang H, Si H, Tang X. Ubiquitin Ligase U-Box51 Positively Regulates Drought Stress in Potato (Solanum tuberosum L.). International Journal of Molecular Sciences. 2024; 25(23):12961. https://doi.org/10.3390/ijms252312961
Chicago/Turabian StyleWei, Meng, Shantwana Ghimire, Anuja Rijal, Kaitong Wang, Huanhuan Zhang, Huaijun Si, and Xun Tang. 2024. "Ubiquitin Ligase U-Box51 Positively Regulates Drought Stress in Potato (Solanum tuberosum L.)" International Journal of Molecular Sciences 25, no. 23: 12961. https://doi.org/10.3390/ijms252312961
APA StyleWei, M., Ghimire, S., Rijal, A., Wang, K., Zhang, H., Si, H., & Tang, X. (2024). Ubiquitin Ligase U-Box51 Positively Regulates Drought Stress in Potato (Solanum tuberosum L.). International Journal of Molecular Sciences, 25(23), 12961. https://doi.org/10.3390/ijms252312961

